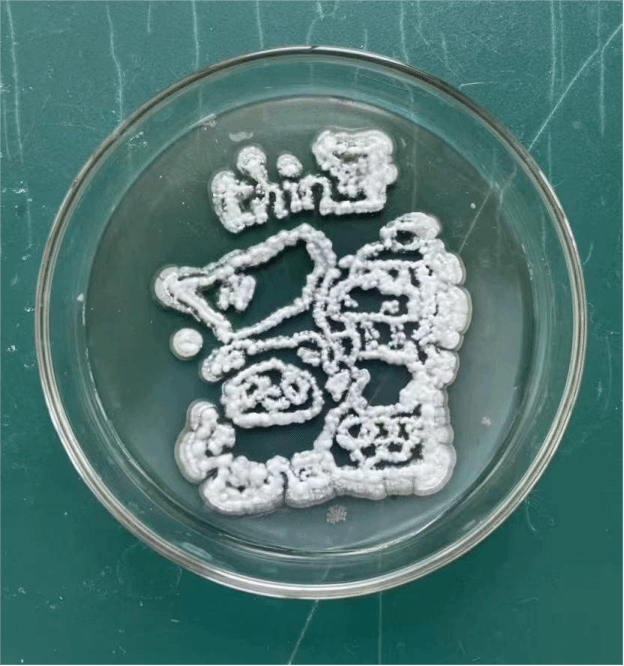

“以青春之名,绘生物图卷”,微生物的世界光怪陆离,蕴含着无穷的魅力。为营造浓厚的校园艺术文化氛围,培养员工对微生物的兴趣,提升创意实践能力,mk体育于2023年5月23日至5月27日特举办微生物创意作画大赛。
参赛员工们充分发挥自己的创意和想象力,妙手绘菌,拾笔成画,以培养皿为画布,以微生物为“颜料”,绘制出一幅幅匠心独运的精美作品。大赛上,同学们侃侃而谈,不仅展示了对微生物学的深入理解,也展现出他们对生物艺术的热爱和追求。参赛作品种类繁多,有的以微生物为灵感,绘制出独特的生物图案;有的则通过微生物的形态和色彩,创作出富有艺术感的作品。每一幅作品都充满了创意和生命力,让人感受到微生物世界的奇妙和美丽,将科学之思与艺术之美的完美结合。
经过评委们的认真评选,本次大赛的优胜者脱颖而出。马琳然、杨思寒等同学荣获一等奖,刘长霞、巩晓菡等同学荣获二等奖,梁超、徐文杰等同学荣获三等奖,赵贵臣、胡惠宁等同学荣获创意奖。 同时,李艳玲、田园、孟超三位老师获得优秀指导老师称号。
此次微生物创意作画大赛的成功举办,不仅激发了员工对微生物学的学习兴趣,也提高了他们的创新实践能力。mk体育力夫科技协会将继续举办类似的活动,为员工们提供更多的实践机会和展示平台,促进生物科学领域的发展和创新。

编辑:郭阳阳、王格格
拍摄:樊慧敏
责编:段赵洋
终审:尹刚
 >>首页
>>正文
>>首页
>>正文

 >>首页
>>正文
>>首页
>>正文
